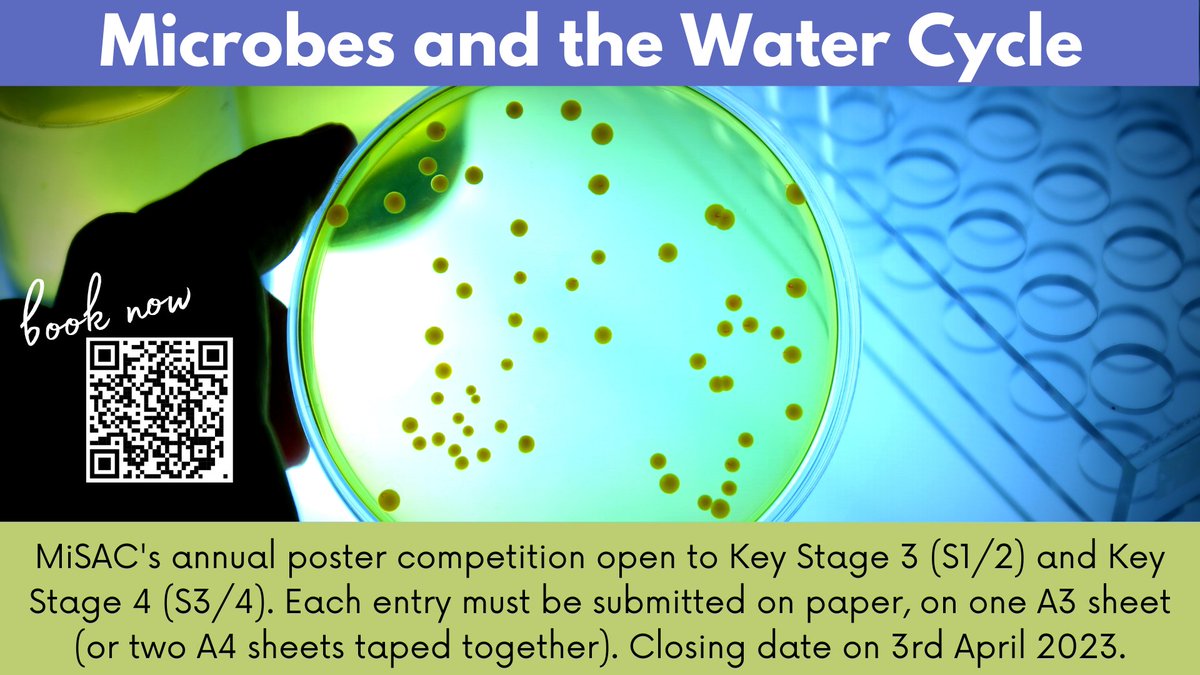
Take part in our annual poster competition, exploring the role of microbes in the water cycle. For more information on how your learners can take part, visit the MiSAC website: misac.org.uk/competition.ht…

MiSAC
@misac_uk
The purpose of the Microbiology in Schools Advisory Committee (MiSAC) is to promote the teaching of microbiology in schools and colleges.
ID: 1540351081007423489
http://misac.org.uk/index.html 24-06-2022 15:10:36
33 Tweet
111 Followers
218 Following